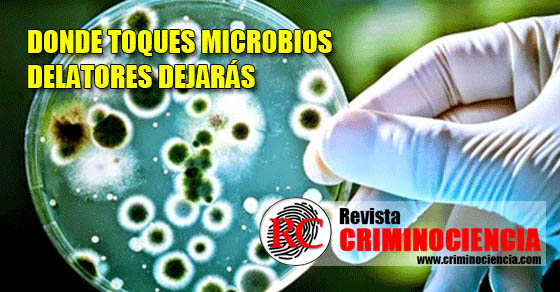

Donde Toques Microbios Delatores Dejarás
Investigadores científicos estadounidenses revelaron que han descubierto como revelar el rastro de cualquier persona mediante los microbios que dejan sus manos. Si un criminal ha tocado alguna parte, esta técnica de identificación humana lo revelará. El científico Noah Fierer señala que cada uno de nosotros abandonamos un rastro único de microbios diariamente. Esta técnica se basa en la cadena genética y posee una precisión de 90%. La metodología que utilizaron se basó en recoger muestras de microbios en las teclas de tres computadoras personales y las cotejaron con los microbios de las manos de sus dueños, y así compararlas con otras muestras que habían sido tomadas de teclados que nunca habían utilizado estas personas. Los resultados fueron positivos, puesto que los microbios de las personas comparado con sus las de sus propias computadoras, coincidieron. Esta prueba también tuvo éxito después de 12 horas de haber sido utilizadas las computadoras.
Fuente: Sanz, Elena. (2010).Las bacterias de tu piel pueden incriminarte. [En línea]. Disponible en: http://www.muyinteresante.es/ciencia/articulo/las-bacterias-de-tu-piel-pueden-incriminarte. Fecha de consulta: 5 de Noviembre de 2014.

